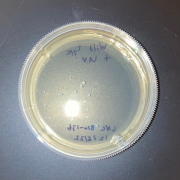

File list
This special page shows all uploaded files.
| Date | Name | Thumbnail | Size | Description | Versions |
|---|---|---|---|---|---|
| 15:44, 16 December 2022 | Negative Control KO4 Trial 3.png (file) |  |
69 KB | 1 | |
| 15:44, 16 December 2022 | Growth Curve KO4 Trial 3.png (file) |  |
64 KB | 1 | |
| 15:43, 16 December 2022 | Negative Control KO4 Trial 2.png (file) |  |
39 KB | 1 | |
| 15:43, 16 December 2022 | Knockout 4 Trial 2.png (file) |  |
66 KB | 1 | |
| 15:42, 16 December 2022 | Negative Control KO4 Trial 1.png (file) |  |
38 KB | 1 | |
| 15:41, 16 December 2022 | Knockout 4 Trial 1.png (file) |  |
34 KB | 1 | |
| 15:27, 16 December 2022 | Negative Control KO5 Trial 3.png (file) |  |
34 KB | 1 | |
| 15:26, 16 December 2022 | Growth Curve KO5 Trial 3.png (file) |  |
40 KB | 1 | |
| 15:26, 16 December 2022 | Negative Control KO5 T2.png (file) |  |
39 KB | 1 | |
| 15:24, 16 December 2022 | Knockout 5 Trial 2.png (file) |  |
33 KB | 1 | |
| 15:24, 16 December 2022 | Negative Control KO5 Trial 1.png (file) |  |
37 KB | 1 | |
| 15:22, 16 December 2022 | Knockout 5 Trial 1.png (file) |  |
29 KB | 1 | |
| 15:19, 16 December 2022 | Negative Control KO3 Trial 3.png (file) |  |
71 KB | 1 | |
| 15:18, 16 December 2022 | Growth Curve KO3 Trial 3.png (file) |  |
67 KB | 1 | |
| 15:18, 16 December 2022 | Negative Control KO3 Trial 2.png (file) |  |
40 KB | 1 | |
| 15:17, 16 December 2022 | Knockout 3 Trial 2.png (file) |  |
66 KB | 1 | |
| 15:15, 16 December 2022 | Negative Control KO3 Trial 1.png (file) |  |
67 KB | 1 | |
| 15:14, 16 December 2022 | Knockout 3 Trial 1.png (file) |  |
35 KB | 1 | |
| 15:04, 16 December 2022 | Negative Control KO2 Trial 3.png (file) |  |
34 KB | 1 | |
| 15:03, 16 December 2022 | Growth Curve KO2 Trial 3.png (file) |  |
76 KB | 1 | |
| 15:02, 16 December 2022 | Negative Control KO2 T2.png (file) |  |
34 KB | 1 | |
| 15:01, 16 December 2022 | Knockout 2 Trial 2.png (file) |  |
31 KB | 1 | |
| 15:00, 16 December 2022 | Negative Control KO2 Trial 1.png (file) |  |
33 KB | 1 | |
| 14:59, 16 December 2022 | Knockout 2 Trial 1.png (file) |  |
39 KB | 1 | |
| 13:43, 16 December 2022 | Negative Control KO1 Trial 3.png (file) |  |
70 KB | 1 | |
| 13:42, 16 December 2022 | Glycerol Growth Curve KO1 T3.png (file) |  |
68 KB | 1 | |
| 13:42, 16 December 2022 | Negative Control KO1 T2.png (file) |  |
67 KB | 1 | |
| 13:41, 16 December 2022 | Glycerol Knockout 1 Trial 2.png (file) |  |
65 KB | 1 | |
| 13:40, 16 December 2022 | Negative Control KO1 Trial 1.png (file) |  |
39 KB | 1 | |
| 13:38, 16 December 2022 | Glycerol Knockout 1 Trial 1.png (file) |  |
33 KB | 1 | |
| 08:07, 14 December 2022 | KO.jpg (file) |  |
33 KB | 1 | |
| 07:48, 14 December 2022 | pilot graph.jpg (file) |  |
222 KB | 1 | |
| 18:55, 13 December 2022 | Well 1 -A.png (file) |  |
27 KB | 1 | |
| 12:54, 13 December 2022 | F graph.png (file) |  |
20 KB | 1 | |
| 12:36, 13 December 2022 | YJL133C-A FA22 UV Trial2.png (file) |  |
3.38 MB | A plate of yeast. | 1 |
| 12:36, 13 December 2022 | YJL133C-A FA22 UV Trial1.png (file) |  |
3.26 MB | A plate of yeast. | 1 |
| 12:36, 13 December 2022 | YJL133C-A FA22 UV NegControl.png (file) |  |
3.07 MB | A plate of yeast with the YJL133C-A gene removed. | 1 |
| 12:32, 13 December 2022 | BY4735 FA22 UV PosControl.png (file) | |
3.21 MB | A plate of BY4735 yeast. | 1 |
| 12:32, 13 December 2022 | BY4735 FA22 UV NegControl.png (file) |  |
3.19 MB | A plate of BY4735 yeast. | 1 |
| 12:14, 13 December 2022 | Yeast Growth in Glycerol Media Exp. 1.png (file) |  |
35 KB | 1 | |
| 12:11, 13 December 2022 | OD 600 original trial Viv.png (file) |  |
122 KB | 1 | |
| 12:10, 13 December 2022 | Yeast Growth in Glucose Media Exp. 1.png (file) |  |
37 KB | 1 | |
| 11:46, 13 December 2022 | Knockout gene v. Caffeine trial 2 Viv.png (file) |  |
82 KB | 1 | |
| 11:43, 13 December 2022 | Best Ethanol KO graph.png (file) |  |
177 KB | 1 | |
| 11:41, 13 December 2022 | Knockout gene v. Caffeine trial 2.png (file) |  |
82 KB | 1 | |
| 12:43, 7 December 2022 | Graph 1.jpg (file) |  |
445 KB | 1 | |
| 12:37, 7 December 2022 | Pilot chart.jpg (file) |  |
445 KB | 1 | |
| 12:06, 7 December 2022 | Pilot Setup.jpg (file) |  |
118 KB | 1 | |
| 12:02, 7 December 2022 | Pilot Experiment setup.jpg (file) |  |
114 KB | 1 | |
| 18:33, 6 December 2022 | Yeast v. time Stock solutions Viv.png (file) |  |
119 KB | 1 |